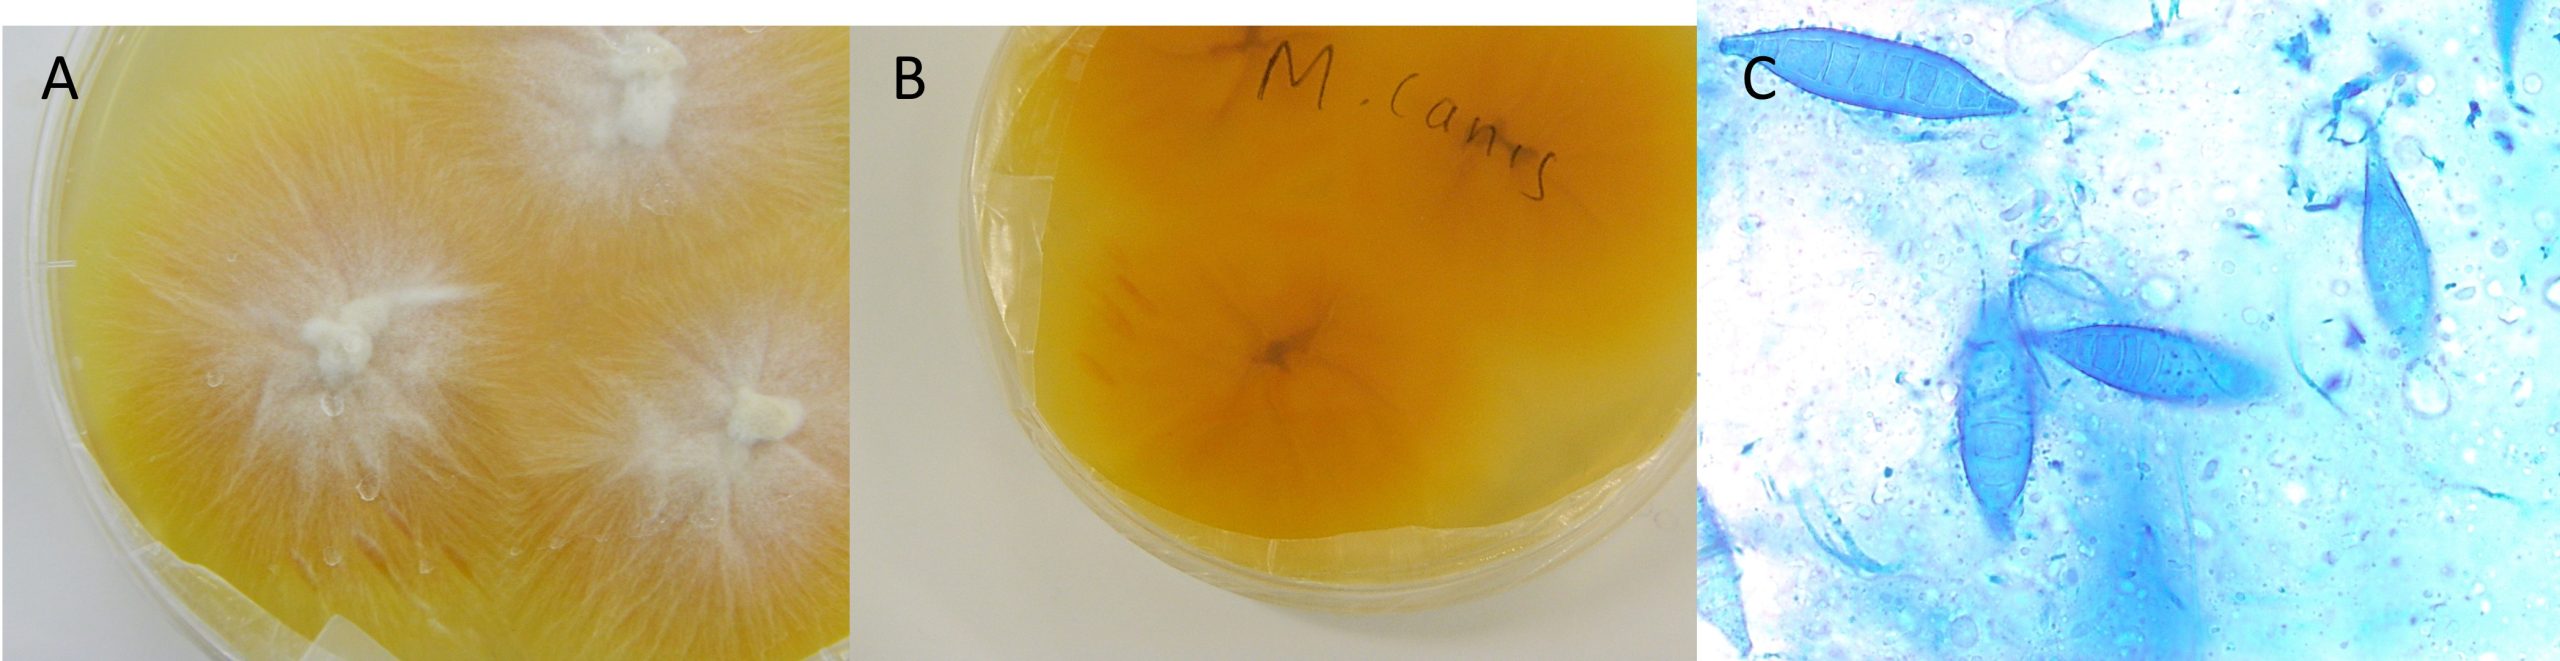

Introduction to Mycoses
Mycoses due to invasive fungi are described by the site of the lesions that they cause:
- superficial
- cutaneous
- sub-cutaneous (nodules, mycetoma)
- deep (localized or disseminated).
superficial mycoses
Superficial mycoses are limited to the outermost layers of the skin, hair and nails. It includes the contagious skin disease, dermatophytosis and infections caused by the yeasts, Malassezia and Candida species. In these infections inflammation can be absent or very mild.
Dermatophytosis: Ascomycota
Dermatophytosis (common names ringworm, tinea, favus) is a common contagious disease in animals and the fungi of animals are known to infect humans (zoonoses). Dermatophytes can be grouped as zoophilic or animal-associated e.g. Microsporum canis in dogs and cats, and Trichophyton verrucosum in cattle and sheep; Nannizzia nana in pigs and Trichophyton equinum in horses); soil-associated or geophilic (Nannizzia gypsea); and anthrophilic or human-associated (called tinea in people) e.g. Trichophyton schoelenii. Fungi in this group produce arthroconidia that either enter hairs or encase hairs and are shed into the environment where they can survive for about 18 months. They will accumulate in environments where there are large numbers of animals and cause disease in young animals that are immunologically naïve. When coming into contact with skin, especially damaged skin, the conidia germinate and start to produce keratinases which breakdown hair and skin.

Thus the disease is observed as patchy areas of hair loss and crusting. As the fungi grow out from a single point of infection, the lesions are often ring-like. Generally the disease is mild. However, in immune-suppressed animals and highly susceptible animals breeds, the lesions can become very extensive.
The pictures below show dermatophytosis in different animal species. All mammals and birds are susceptible to dermatophytosis




Note that all animal-associated dermatophytes are zoonotic. Below is a picture of a scalp lesion of a boy that was infected from the dog shown in the left picture above.

Antigens from the fungi will diffuse to the skin histiocytes resulting in a protective immune response and elimination of the fungi. Occasionally inflammation will occur resulting in an inflammatory response. Most animals self-cure with complete healing after 2 months of infection. Due to slow hair regrowth fungal cure occurs a few weeks prior to clinical cure. Treatment of animals does not usually speed-up recovery, but it does reduce environmental fungal dissemination. Vaccines developed for cattle dermatophytes i.e. T. verrucosum have been found to be cross-protective against other dermatophytes. However, due to the mild nature of the disease and good protective immunity, no vaccine has proven to be a commercial success.
Diagnosis of dermatophytosis
- Clinical signs of patchy hair loss, usually not itchy, in young or immunosuppressed animals that have been recently introduced into a household or where there are large groups of animals.
- Dogs and cats can be examined under a Wood’s lamp (UV lamp) to check for fluorescing hairs. (M. canis)
- Collect hair plucks, tooth brushings or a skin wedge biopsy from the edge of the lesions.
- Affected hairs are usually weak and break easily.

Examine the hairs under the microscope. Clearing solutions such as 10% potassium hydroxide or lactophenol will assist you in identifying the arthroconidia on (ectothrix) or in (endothrix) the hairs. Examine for damaged hair under low power (10x objective) and then the damaged hairs at high power for arthroconidia (40x objective) – circular clear structures seen in the picture below. Note that fungal hyphae are surrounding the hair in the picture as well.

Due to lots debris in hair and skin samples, the arthroconidia and fungal hyphae can be difficult to see on cytology. Diagnosis is also based on a positive culture on a selective agar known as dermatophyte test media. Hairs or skin scrapings at the edge of lesions or loose hairs collected with a new toothbrush are placed on Dermatophyte test medium and incubated at room temperature for up to 5 days. Dermatophytes being keratinase and other protease producers tend to preferentially enzymatically degrade proteins producing an alkaline product which turns the phenol red indicator in the media red.

Identification of the dermatophytes can be done morphologically based on colony growth and microscopic identification of typical asexual reproductive structures. Below is a picture of the identification characteristics of Microsporum canis. The fungal identification atlas in the practical Manual shows how to identify the other dermatophyte species.
2. Malassezia pachydermatitis : Ascomycotina
Malassezia pachydermatitis causes a chronic otitis externa or generalised superficial, seborreic dermatitis in predisposed dogs and rarely in cats. Dogs predisposed to ear infections are those with hanging ears that swim e.g. spaniels. This yeast which is part of the normal skin and ear microflora has a preference for sebaceous secretions of the epidermis and will proliferate when the skin produces increased sebum as a protective measure. Thus affected ears often have a brown waxy exudate and affected skin has a greasy feel.

Diagnosis
The presence of Malassezia species is revealed by cytologically examining stained smears of ear exudate or skin scrapings. It is a small yeast with budding that shows a scar. It will also produce “snowman” forms = mother cell with smaller daughter cell budding. The diagnosis of Malassezia otitis should only be considered if high numbers of budding yeasts are present (>5/high power field) in the ear exudate. Malassezia can also be cultured on artificial media. M. pachydermatis, the most common species affecting dogs will grow easily on Sabouraud’s dextrose agar. However, other species require sterols for growth and thus should be grown on Dixon’s agar.

Note that antifungal resistance to Malassezia is increasingly being recognised. Thus, antifungal testing should be carried out.
3. Candidiasis : Ascomycotina
Candida species are commensals on the mucosae and intestinal tract of animals. They can cause a superficial infection of the skin, oral cavity and genital mucosae. Candida species infects young animals or these with a defective immune system causing thrush or candidiasis. Common infections in animals include crop infections of hatchling birds and gastroenteritis in piglets and calves. Gastrointestinal infections due to Candida species are more common in animals that have been on prolonged antibiotic therapy. This type of infection responds well to antifungal therapy. People can also be infected either orally (suckling babies) or venereally. Occasionally they will disseminate to deeper tissue structures and cause a systemic mycosis.
A number of virulence factors have been identified in Candida species. They include:
- Adhesins: Various cell wall components are associated with adherence to extracellular matrix proteins of the host
- Cell wall glycoproteins: May have an endotoxin-like activity
- Germ tube formation: Develop into septate branching mycelium which makes it difficult for phagocytosis and masks the Beta 1,3 glucans from the immune system.
- In vivo, mycelial growth is associated with active proliferation and invasiveness


Diagnosis of candidiasis
The typical pear-shape and narrow-waisted budding of Candida species makes it recognizable in cytological preparations of affected tissues. However, speciation is only done on fungal culture with identification based on biochemical profiling of the yeast. A more rapid identification of Candida albicans is using the germ test were the yeasts are incubated for one to three hours in plasma enriched with glucose.


Note that antifungal resistance is developing rapidly. thus, antifungal testing should be carried out.
END OF CHAPTER